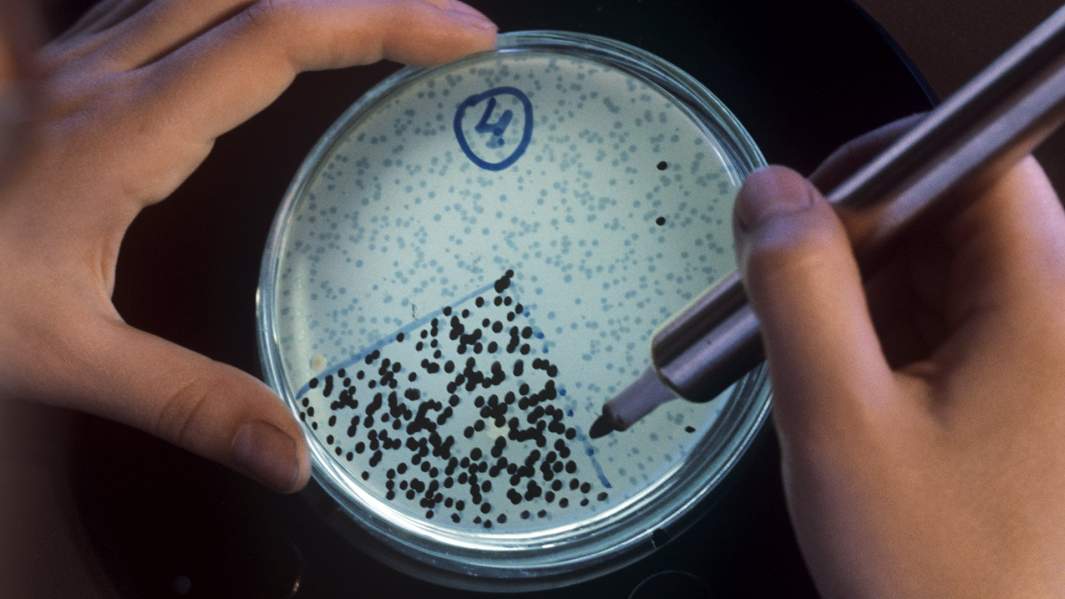
Биоинженерия

Сальто-иммортале: умирать нам рановато

Палеонтолог и биолог из Сиэтла Питер Уорд с очень сдержанным оптимизмом смотрит на проблему достижения человечеством в перспективе если не вечной жизни, то значительного увеличения ее продолжительности. Свои соображения он вкратце изложил в доходчивой научно-популярной стилистике — критик Лидия Маслова представляет книгу недели, специально для «Известий».
Питер Уорд
«Цена бессмертия. Гонка за последней мечтой человечества»
Москва: Издательство АСТ, 2023. — перевод с английского Д.С. Дамте. — 320 с.
Главный вопрос, по мнению автора книги «Цена бессмертия», даже не в технической возможности достичь заветной цели, а в том, как человечество морально и психологически справится с ситуацией, в которой умирать станет необязательно. Интересная специфика книги Уорда, рассматривающей проблему бессмертия практически со всех возможных сторон, еще и в том, что он начал работу над ней до пандемии COVID-19, а закончил уже после. «Подобно ультрафиолетовому лучу на грязной кровати в мотеле, COVID-19 высветил темные и шаткие основы, на которых построено наше общество», — констатирует автор книги.
Наблюдения за пандемийным поведением как отдельных граждан, так и целых государств с их далекими от совершенства системами здравоохранения (американскую он особенно неустанно ругает как самую коррумпированную на свете), явно добавили профессору скепсиса в оценке человеческой способности поступать разумно, руководствуясь не своими эгоистическими желаниями, а соображениями общечеловеческого блага.

«Учитывая жестокость и страдания, которые мы причиняем нашим собратьям-животным и земле, сложно утверждать, что мы заслуживаем того, чтобы жить дольше», — пеняет человечеству Уорд в эпилоге, действие которого происходит в Москве в ноябре 2021-го. Пытливый американец приезжает на метро в Коньково пообщаться с Анастасией Гачевой, директором музея-библиотеки философа Николая Федорова, одного из основоположников «русского космизма» и кумира американских имморталистов. С ними Уорд проводит много времени в первых главах книги, иллюстрирующей поистине «лихорадочную одержимость» желающих жить вечно.
Знакомство с колоритной имморталистской публикой начинается с Церкви вечной жизни во Флориде. Это пестрое сборище довольно экстравагантных личностей, благодаря которым «Цена бессмертия» превращается в остросюжетное чтение, не лишенное элемента трагикомичности. В инстинктивном человеческом стремлении убежать от неизбежного дело довольно часто доходит до смешного. Например, когда речь идет о такой практике, как крионика, то есть замораживание мертвых тел в надежде оживить их позже, когда позволит развитие науки. «У крионики яркая и необычная история, и она по-прежнему остается передовой наукой, которую одни осуждают как бессмыслицу, а другие пропагандируют как эффективный план Б», — пишет Уорд перед тем, как рассказать о нескольких наиболее известных попытках замораживания. Благодаря им его книга местами превращается в совершеннейшую черную комедию, скажем, в третьей главе под названием «Любопытный случай исчезновения замороженной головы».
В ней речь идет о «вундеркинде» крионики Майке Федоровиче, который взял себе амбициозный творческий псевдоним Дарвин и пробовал замораживать животных еще в 1967 году, двенадцатилетним подростком. Возмужав, Дарвин-Федорович пришел к конструктивной идее, что из всего человеческого организма брать в будущее имеет смысл только голову (что значительно упрощает жизнь сторонникам крионики). Телесные ощущения всё равно генерируются мозгом, поэтому недолговечное тело в любом случае — расходный материал, за который не стоит цепляться. В 1987-м Майку Дарвину пришлось стать героем громкого скандала с замороженной головой одной пациентки, хотя судебный процесс ему в итоге удалось выиграть: «Вечером местный новостной канал рассказал несколько особенно жутких историй. Был осужден убийца с бензопилой, пекарь упал в чан с тестом и чуть не умер, а группа крионистов якобы отрубила голову старушке, когда та была еще жива».
Рискованная, но по-своему увлекательная, как всякая авантюра, крионика — это, так сказать, заря иммортализма, который жадно следит за развитием науки. «Цена бессмертия» освещает все новейшие достижения в попытке победить старение и умирание и передовые медицинские технологии: генную терапию и редактирование генов, нанотехнологии, лечение стволовыми клетками. Не обойдены вниманием и «более спекулятивные сферы» трансгуманизма — создание «мозгового интерфейса», идея сканирования мозга и резервного копирования человеческого сознания в компьютер. Об аналогичных технологиях, которые в обозримом будущем вполне могут сделать некоторые формы бессмертия реальными, пишет в своих последних романах такой исследователь трансгуманизма и проницательный футуролог, как Виктор Пелевин, у которого богатые получают возможность как угодно долго хранить свой мозги в специальной банке.
Неизвестно, читал ли Питер Уорд Пелевина, в чьей картине мира у бедных шанса на бессмертие нет, но с другим русским мыслителем, Николаем Федоровым, он решительно солидарен в его критике капитализма: «Если бы у меня был выбор между духовной, всеобъемлющей версией вечности Федорова и двухуровневым миром вечной жизни для технологической элиты, я бы, конечно, выбрал точку зрения давно умершего русского философа». Проблема неравенства, которое человечество никак не может преодолеть, — одна из центральных для Уорда, размышляющего, пусть даже несколько утопически, о необходимости глобального переустройства человеческой жизни и создания системы, обеспечивающей всеобщее равенство, когда научные разработки по отодвиганию старения и смерти «будут доступны всем, а не только тем, у кого достаточно денег».
В противном случае бессмертие просто лишается общечеловеческого смысла: прежде чем его добиваться, неплохо бы сначала «построить мир, достойный более длительного существования». А пока теоретическая возможность вечной жизни остается утешительной мечтой, позволяющей приглушить эгоистический страх смерти в масштабе отдельно взятой личности, но не решающей или даже грозящей обострить проблемы человечества в целом: «Вкладывая деньги в перспективные технологии вроде крионики или в непроверенные причуды в виде биологически активных добавок, мы ничего не сделаем для облегчения сегодняшних глобальных страданий».